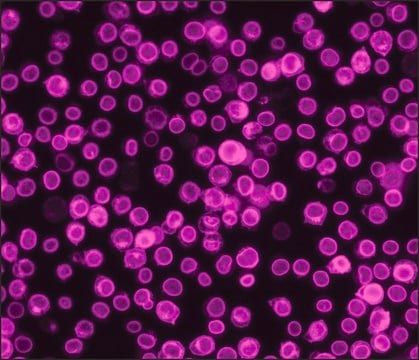
Img

SAB4600013
Anti-Mouse IgG (H+L), CF™ 350 antibody produced in goat
~2 mg/mL, affinity isolated antibody
Manufacturer: Sigma Aldrich
Select a Size
| Pack Size | SKU | Availability | Price |
|---|---|---|---|
| 50 μL | SAB4600013-50-μL | In Stock | ₹ 9,002.10 |
| 250 μL | SAB4600013-250-μL | In Stock | ₹ 18,781.20 |
SAB4600013 - 50 μL
In Stock
Quantity
1
Base Price: ₹ 9,002.10
GST (18%): ₹ 1,620.378
Total Price: ₹ 10,622.478
biological source
goat
Quality Level
100
conjugate
CF™ 350 conjugate
antibody form
affinity isolated antibody
antibody product type
secondary antibodies
clone
polyclonal
form
buffered aqueous solution
species reactivity
mouse
concentration
~2 mg/mL
technique(s)
flow cytometry: 1-10 μg/mLimmunocytochemistry: suitableimmunohistochemistry: suitableindirect immunofluorescence: 1-10 μg/mL
Description
- Specificity: Binds all mouse IgGs
- Immunogen: mouse IgG (H+L)
- Features and Benefits: Evaluate our antibodies with complete peace of mind. If the antibody does not perform in your application, we will issue a full credit or replacement antibody. Learn more.
- Physical form: Supplied in phosphate buffered saline with 0.05% sodium azide, 50% glycerol and 2 mg/mL bovine serum albumin.
- Preparation Note: Protect from light.
- Legal Information: This product is distributed by Sigma-Aldrich Co. under the authorization of Biotium, Inc. This product is covered by one or more US patents and corresponding patent claims outside the US patents or pending applications owned or licensed by Biotium, Inc. including without limitation: 12/334,387; 12/607,915; 12/699,778; 12/850,578; 61/454,484. In consideration of the purchase price paid by the buyer, the buyer is hereby granted a limited, non-exclusive, non-transferable license to use only the purchased amount of the product solely for the buyer′s own internal research in a manner consistent with the accompanying product literature. Except as expressly granted herein, the sale of this product does not grant to or convey upon the buyer any license, expressly, by implication or estoppel, under any patent right or other intellectual property right of Biotium, Inc. Buyer shall not resell or transfer this product to any third party, or use the product for any commercial purposes, including without limitation, any diagnostic, therapeutic or prophylactic uses. This product is for research use only. Any other uses, including diagnostic uses, require a separate license from Biotium, Inc. For information on purchasing a license to use this product for purposes other than research, contact Biotium, Inc., 3159 Corporate Place, Hayward, CA 94545, Tel: (510) 265-1027. Fax: (510) 265-1352. Email: btinfo@biotium.com.
- Disclaimer: Unless otherwise stated in our catalog or other company documentation accompanying the product(s), our products are intended for research use only and are not to be used for any other purpose, which includes but is not limited to, unauthorized commercial uses, in vitro diagnostic uses, ex vivo or in vivo therapeutic uses or any type of consumption or application to humans or animals.
SAFETY INFORMATION
WGK
WGK 2
Flash Point(F)
Not applicable
Flash Point(C)
Not applicable
Compare Similar Items
Show Difference
biological source: goat
Quality Level: 100
conjugate: CF™ 350 conjugate
antibody form: affinity isolated antibody
antibody product type: secondary antibodies
clone: polyclonal
form: buffered aqueous solution
species reactivity: mouse
concentration: ~2 mg/mL
technique(s): flow cytometry: 1-10 μg/mLimmunocytochemistry: suitableimmunohistochemistry: suitableindirect immunofluorescence: 1-10 μg/mL
biological source:
goat
Quality Level:
100
conjugate:
CF™ 350 conjugate
antibody form:
affinity isolated antibody
antibody product type:
secondary antibodies
clone:
polyclonal
form:
buffered aqueous solution
species reactivity:
mouse
concentration:
~2 mg/mL
technique(s):
flow cytometry: 1-10 μg/mLimmunocytochemistry: suitableimmunohistochemistry: suitableindirect immunofluorescence: 1-10 μg/mL
biological source: goat
Quality Level: 100
conjugate: CF™ 350 conjugate
antibody form: affinity isolated antibody
antibody product type: secondary antibodies
clone: polyclonal
form: buffered aqueous solution
species reactivity: rabbit
concentration: ~2 mg/mL
technique(s): flow cytometry: 1-10 μg/mLimmunocytochemistry: suitableimmunohistochemistry: suitableindirect immunofluorescence: 1-10 μg/mL
biological source:
goat
Quality Level:
100
conjugate:
CF™ 350 conjugate
antibody form:
affinity isolated antibody
antibody product type:
secondary antibodies
clone:
polyclonal
form:
buffered aqueous solution
species reactivity:
rabbit
concentration:
~2 mg/mL
technique(s):
flow cytometry: 1-10 μg/mLimmunocytochemistry: suitableimmunohistochemistry: suitableindirect immunofluorescence: 1-10 μg/mL
biological source: goat
Quality Level: 100
conjugate: CF™ 350 conjugate
antibody form: affinity isolated antibody
antibody product type: secondary antibodies
clone: polyclonal
form: buffered aqueous solution
species reactivity: rabbit
concentration: ~2 mg/mL
technique(s): flow cytometry: 1-10 μg/mLimmunocytochemistry: suitableimmunohistochemistry: suitableindirect immunofluorescence: 1-10 μg/mL
biological source:
goat
Quality Level:
100
conjugate:
CF™ 350 conjugate
antibody form:
affinity isolated antibody
antibody product type:
secondary antibodies
clone:
polyclonal
form:
buffered aqueous solution
species reactivity:
rabbit
concentration:
~2 mg/mL
technique(s):
flow cytometry: 1-10 μg/mLimmunocytochemistry: suitableimmunohistochemistry: suitableindirect immunofluorescence: 1-10 μg/mL
biological source: goat
Quality Level: 100
conjugate: CF™ 350 conjugate
antibody form: affinity isolated antibody
antibody product type: secondary antibodies
clone: polyclonal
form: buffered aqueous solution
species reactivity: rat
concentration: ~2 mg/mL
technique(s): flow cytometry: 1-10 μg/mLimmunocytochemistry: suitableimmunohistochemistry: suitableindirect immunofluorescence: 1-10 μg/mL
biological source:
goat
Quality Level:
100
conjugate:
CF™ 350 conjugate
antibody form:
affinity isolated antibody
antibody product type:
secondary antibodies
clone:
polyclonal
form:
buffered aqueous solution
species reactivity:
rat
concentration:
~2 mg/mL
technique(s):
flow cytometry: 1-10 μg/mLimmunocytochemistry: suitableimmunohistochemistry: suitableindirect immunofluorescence: 1-10 μg/mL